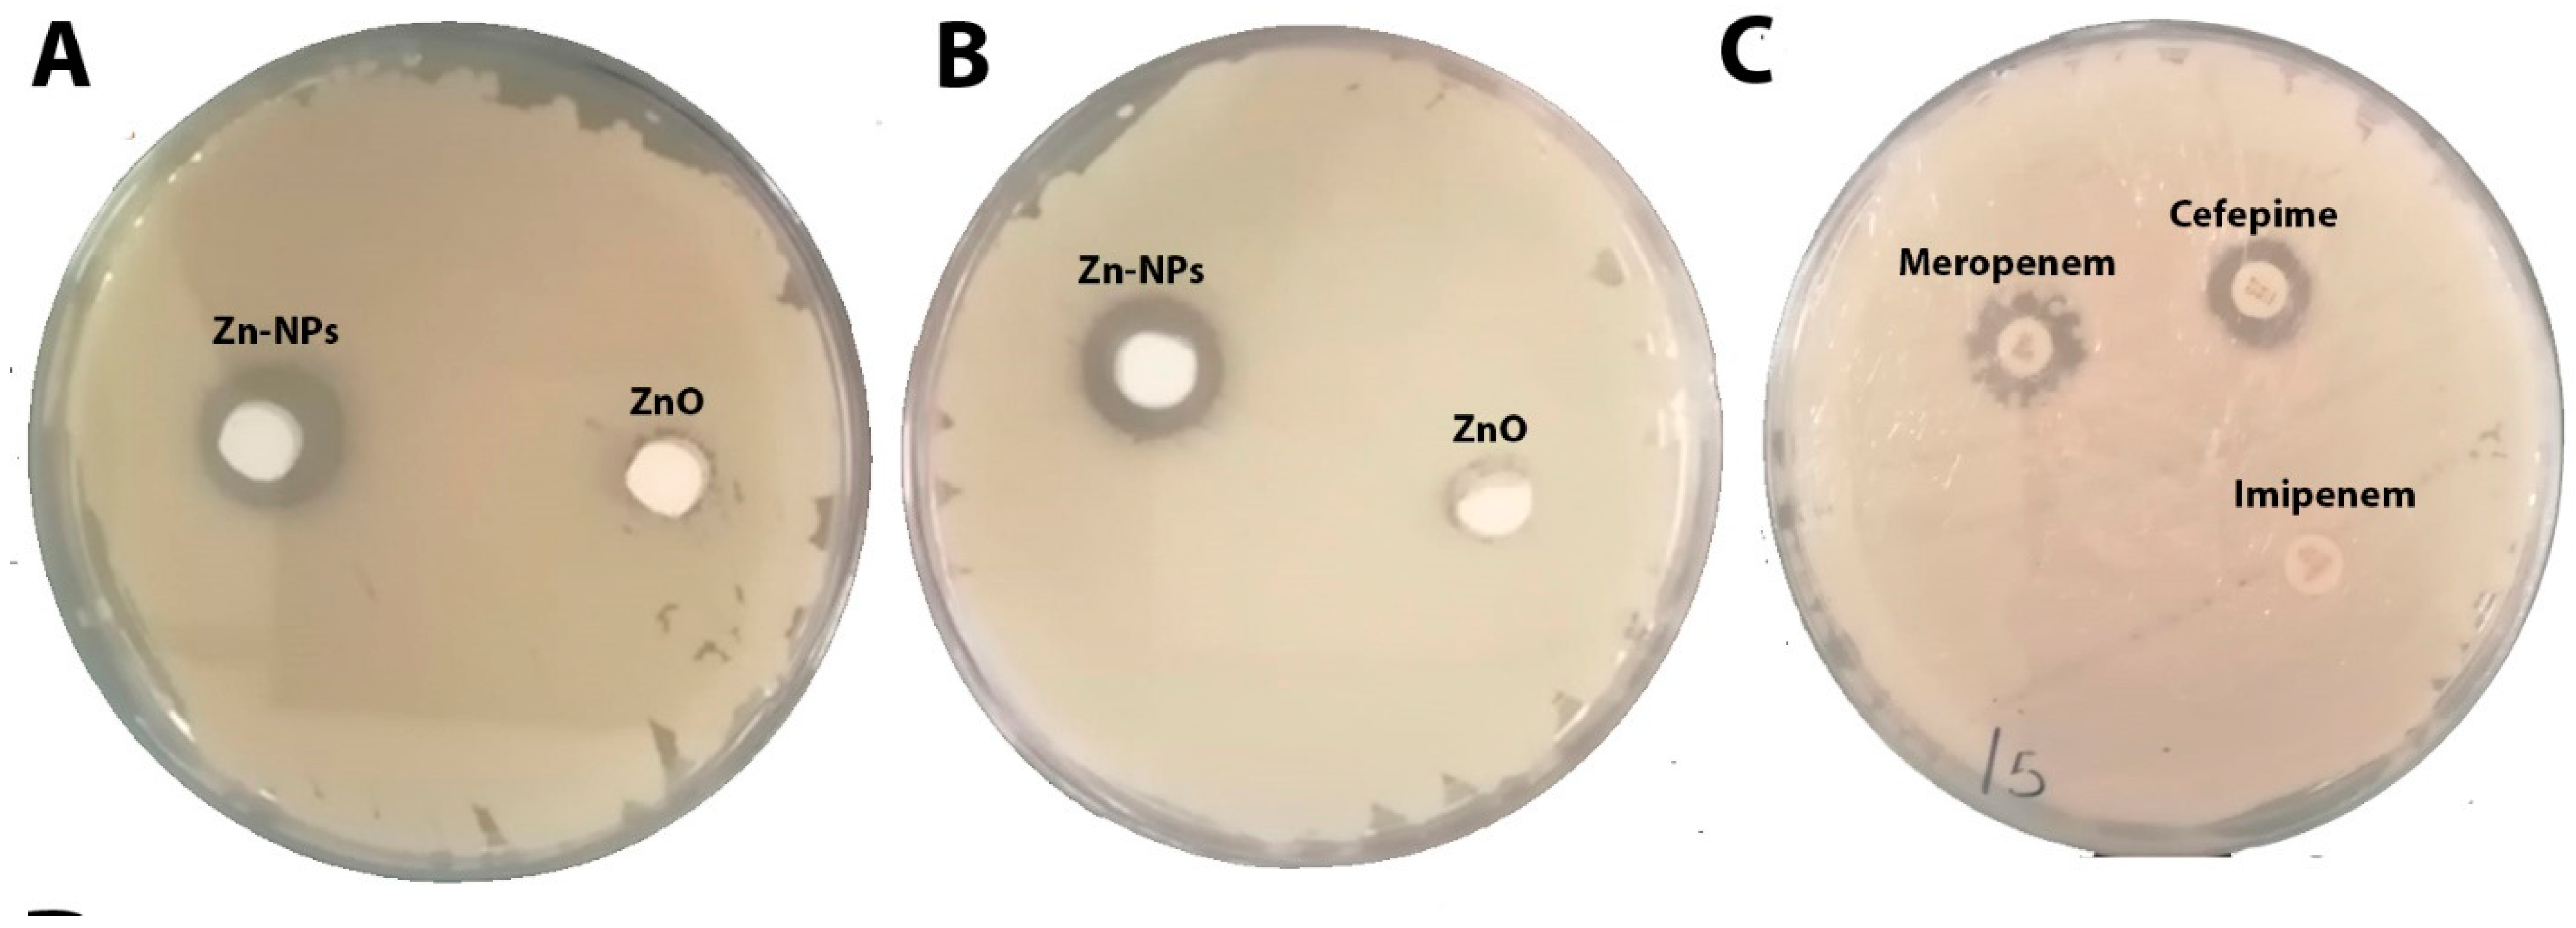
Molecules 28 02510 g009 Molecules 28 02510 g009

Molecular Dynamic Analysis of Carbapenem-Resistant Klebsiella pneumonia’s Porin Proteins with Beta Lactam Antibiotics and Zinc Oxide Nanoparticles
Abstract
1. Introduction
2. Results and Discussion
2.1. Zinc Oxide Nanoparticles’ Characterizations
2.2. In Silico Studies
2.2.1. Quantitative Structure–Activity Relationship (QSAR) Studies
2.2.2. Molecular Docking Analysis
Interaction Analysis of Protein
2.2.3. MD Simulation Study
Stability of Protein–Ligand Complexes
Protein and Ligand Properties from MD Simulation Analysis
Protein Ligand Contacts and Interacting Bond
2.3. Antibacterial Activity
Zone of Inhibition of ZnO-NPs and the Selected Antibiotics
3. Methodology
3.1. Synthesis of Zinc Oxide Nanoparticles (ZnO-NPs) and Characterization
3.2. Protein Targets and Ligands
3.3. Molecular Docking Study
3.4. QSAR Studies
3.5. Molecular Dynamics Simulation
3.6. Antibacterial Activity
4. Conclusions
Author Contributions
Funding
Institutional Review Board Statement
Informed Consent Statement
Data Availability Statement
Conflicts of Interest
Sample Availability
References
- Unit, M.; Arabia, S.; Arabia, S.; Faisal, K.; Hospital, S.; Arabia, S. Comparison of molecular and phenotypic methods for the detection and characterization of carbapenem resistant enterobacteriaceae. Acta Microbiol. Immunol. Hung. 2016, 63, 69–81. [Google Scholar] [CrossRef]
- Aldrees, M.; Al, S.M.; Alrodayyan, M.; Aldughashem, F.A.; Balkhy, H.H. International Journal of Infectious Diseases Multi-drug carbapenem-resistant Klebsiella pneumoniae infection carrying the OXA-48 gene and showing variations in outer membrane protein 36 causing an outbreak in a tertiary care hospital in Riyadh, Saudi Ara. Int. J. Infect. Dis. 2014, 28, 186–192. [Google Scholar] [CrossRef]
- Munoz-Price, L.S.; Poirel, L.; Bonomo, R.A.; Schwaber, M.J.; Daikos, G.L.; Cormican, M.; Cornaglia, G.; Garau, J.; Gniadkowski, M.; Hayden, M.K.; et al. Clinical epidemiology of the global expansion of Klebsiella pneumoniae carbapenemases. Lancet Infect. Dis. 2013, 13, 785–796. [Google Scholar] [CrossRef]
- Perez, F.; Villegas, M.V. The role of surveillance systems in confronting the global crisis of antibiotic-resistant bacteria. Curr. Opin. Infect. Dis. 2015, 28, 375–383. [Google Scholar] [CrossRef] [PubMed]
- Al-Zahrani, I.A.; Alasiri, B.A. The emergence of carbapenem-resistant Klebsiella pneumoniae isolates producing OXA-48 and NDM in the Southern (Asir) Province, Saudi Arabia. Saudi Med. J. 2018, 39, 23–30. [Google Scholar] [CrossRef] [PubMed]
- Rasha, E.; Monerah, A.; Manal, A.; Rehab, A.; Mohammed, D.; Doaa, E. Biosynthesis of zinc oxide nanoparticles from Acacia nilotica (L.) extract to overcome carbapenem-resistant Klebsiella pneumoniae. Molecules 2021, 26, 1991. [Google Scholar] [CrossRef] [PubMed]
- Zowawi, H.M.; Sartor, A.L.; Balkhy, H.H.; Walsh, T.R.; Johani, M.A.; Aljindan, R.Y.; Alfaresi, M.; Ibrahim, E.; Al-jardani, A.; Al-abri, S.; et al. Molecular Characterization of Carbapenemase-Producing Escherichia coli and Klebsiella pneumoniae in the Countries of the Gulf Cooperation Council : Dominance of OXA-48 and NDM Producers. Antimicrob. Agents Chemother. 2014, 58, 3085–3090. [Google Scholar] [CrossRef]
- Alotaibi, F. Carbapenem-Resistant Enterobacteriaceae: An update narrative review from Saudi Arabia. J. Infect. Public Health 2019, 12, 465–471. [Google Scholar] [CrossRef]
- Meletis, G. Carbapenem resistance: Overview of the problem and future perspectives. Ther. Adv. Infect. Dis. 2016, 3, 15–21. [Google Scholar] [CrossRef]
- Papp-Wallace, K.M.; Endimiani, A.; Taracila, M.A.; Bonomo, R.A. Carbapenems: Past, present, and future. Antimicrob. Agents Chemother. 2011, 55, 4943–4960. [Google Scholar] [CrossRef]
- Rasha, E.; Alkhulaifi, M.M.; AlOthman, M.; Khalid, I.; Doaa, E.; Alaa, K.; Awad, M.A.; Abdalla, M. Effects of Zinc Oxide Nanoparticles Synthesized Using Aspergillus niger on Carbapenem-Resistant Klebsiella pneumonia In Vitro and In Vivo. Front. Cell. Infect. Microbiol. 2021, 11, 748739. [Google Scholar] [CrossRef] [PubMed]
- Reddy, L.S.; Nisha, M.M.; Joice, M.; Shilpa, P.N. Antimicrobial activity of zinc oxide (ZnO) nanoparticle against Klebsiella pneumoniae. Pharm. Biol. 2014, 52, 1388–1397. [Google Scholar] [CrossRef]
- Ghasemi, F.; Jalal, R. Antimicrobial action of zinc oxide nanoparticles in combination with ciprofloxacin and ceftazidime against multidrug-resistant Acinetobacter baumannii. J. Glob. Antimicrob. Resist. 2016, 6, 118–122. [Google Scholar] [CrossRef] [PubMed]
- Abdalla, M.; Mohapatra, R.K.; Sarangi, A.K.; Mohapatra, P.K.; Eltayb, W.A.; Alam, M.; El-Arabey, A.A.; Azam, M.; Al-Resayes, S.I.; Seidel, V.; et al. In silico studies on phytochemicals to combat the emerging COVID-19 infection. J. Saudi Chem. Soc. 2021, 25, 101367. [Google Scholar] [CrossRef]
- Fernández-Prada, C.; Douanne, N.; Minguez-Menendez, A.; Pena, J.; Tunes, L.G.; Pires, D.E.V.; Monte-Neto, R.L. Repurposed Molecules: A New Hope in Tackling Neglected Infectious Diseases. Silico Drug Des. 2019, 119–160. [Google Scholar] [CrossRef]
- Richardson, P.M.; Harborne, J.B. Phytochemical Methods: A Guide to Modern Techniques of Plant Analysis. Second Edition. Brittonia 1990, 42, 115. [Google Scholar] [CrossRef]
- Wikler, M.A. Methods for dilution antimicrobial susceptibility tests for bacteria that grow aerobically: Approved standard. Clin. Lab. Stand. Inst. 2012, 32, M7–A9. [Google Scholar]
- Yousef, J.M.; Danial, E.N. In Vitro Antibacterial Activity and Minimum Inhibitory Concentration of Zinc Oxide and Nano-particle Zinc oxide Against Pathogenic Strains. Int. J. Health Sci. 2012, 2, 38–42. [Google Scholar] [CrossRef]
- Mirzaei, H.; Darroudi, M. Zinc oxide nanoparticles: Biological synthesis and biomedical applications. Ceram. Int. 2017, 43, 907–914. [Google Scholar] [CrossRef]
- Tiwari, V.; Mishra, N.; Gadani, K.; Solanki, P.S.; Shah, N.A.; Tiwari, M. Mechanism of anti-bacterial activity of zinc oxide nanoparticle against Carbapenem-Resistant Acinetobacter baumannii. Front. Microbiol. 2018, 9, 1218. [Google Scholar] [CrossRef]
- Alameen, A.A.; Abdalla, M.; Alshibl, H.M.; AlOthman, M.R.; Alkhulaifi, M.M.; Mirgany, T.O.; Elsayim, R. In-silico studies of glutathione peroxidase4 activators as candidate for multiple sclerosis management. J. Saudi Chem. Soc. 2022, 26, 101554. [Google Scholar] [CrossRef]
- Hendi, A.A.; Virk, P.; Awad, M.A.; Elobeid, M.; Ortashi, K.M.O.; Alanazi, M.M.; Alkallas, F.H.; Almoneef, M.M.; Abdou, M.A. In Silico Studies on Zinc Oxide Based Nanostructured Oil Carriers with Seed Extracts of Nigella sativa and Pimpinella anisum as Potential Inhibitors of 3CL Protease of SARS-CoV-2. Molecules 2022, 27, 4301. [Google Scholar] [CrossRef] [PubMed]
- Aldalbahi, A.; Alterary, S.; Ali Abdullrahman Almoghim, R.; Awad, M.A.; Aldosari, N.S.; Fahad Alghannam, S.; Nasser Alabdan, A.; Alharbi, S.; Ali Mohammed Alateeq, B.; Abdulrahman Al Mohsen, A.; et al. Greener Synthesis of Zinc Oxide Nanoparticles: Characterization and Multifaceted Applications. Molecules 2020, 25, 4198. [Google Scholar] [CrossRef] [PubMed]
- Ononamadu, C.J.; Abdalla, M.; Ihegboro, G.O.; Li, J.; Owolarafe, T.A.; John, T.D.; Tian, Q. In silico identification and study of potential anti-mosquito juvenile hormone binding protein (MJHBP) compounds as candidates for dengue virus—Vector insecticides. Biochem. Biophys. Rep. 2021, 28, 101178. [Google Scholar] [CrossRef] [PubMed]
- Owoloye, A.J.; Ligali, F.C.; Enejoh, O.A.; Musa, A.Z.; Aina, O.; Idowu, E.T.; Oyebola, K.M. Molecular docking, simulation and binding free energy analysis of small molecules as Pf HT1 inhibitors. PLoS ONE 2022, 17, e0268269. [Google Scholar] [CrossRef]
- Samad, A.; Huq, M.A.; Rahman, M.S. Bioinformatics approaches identified dasatinib and bortezomib inhibit the activity of MCM7 protein as a potential treatment against human cancer. Sci. Rep. 2022, 12, 1539. [Google Scholar] [CrossRef]
- Sharma, N.; Singh, V.; Pandey, A.K.; Mishra, B.N.; Kulsoom, M.; Dasgupta, N.; Khan, S.; El-Enshasy, H.A.; Haque, S. Preparation and evaluation of the ZnO NP–ampicillin/sulbactam nanoantibiotic: Optimization of formulation variables using RSM coupled GA method and antibacterial activities. Biomolecules 2019, 9, 764. [Google Scholar] [CrossRef]
- ur Rashid, H.; Ahmad, N.; Abdalla, M.; Khan, K.; Martines, M.A.U.; Shabana, S. Molecular docking and dynamic simulations of Cefixime, Etoposide and Nebrodenside A against the pathogenic proteins of SARS-CoV-2. J. Mol. Struct. 2021, 1247, 131296. [Google Scholar] [CrossRef]
- Lobanov, M.Y.; Bogatyreva, N.S.; Galzitskaya, O. V Radius of gyration as an indicator of protein structure compactness. Mol. Biol. 2008, 42, 623–628. [Google Scholar] [CrossRef]
- Mugumbate, G.; Overington, J.P. The relationship between target-class and the physicochemical properties of antibacterial drugs. Bioorganic Med. Chem. 2015, 23, 5218–5224. [Google Scholar] [CrossRef]
- Kalpana, V.N.; Devi Rajeswari, V. A Review on Green Synthesis, Biomedical Applications, and Toxicity Studies of ZnO NPs. Bioinorg. Chem. Appl. 2018, 3–4. [Google Scholar] [CrossRef] [PubMed]
- Ifeanyichukwu, U.L.; Fayemi, O.E.; Ateba, C.N. Green synthesis of zinc oxide nanoparticles from pomegranate (punica granatum) extracts and characterization of their antibacterial activity. Molecules 2020, 25, 4521. [Google Scholar] [CrossRef] [PubMed]
- Kumar, P.; Arya, A. Ramachandran Plot: A simplified approach. Pathfind. Res. Train. Found. 2018, 1–7. [Google Scholar]
- Levison, M.E.; Levison, J.H. Pharmacokinetics and Pharmacodynamics of Antibacterial Agents. Infect Dis. Clin. N. Am. 2009, 23, 791–815. [Google Scholar] [CrossRef] [PubMed]
- Kowalska-Krochmal, B.; Dudek-Wicher, R. The minimum inhibitory concentration of antibiotics: Methods, interpretation, clinical relevance. Pathogens 2021, 10, 165. [Google Scholar] [CrossRef]
- Clinical and Laboratory Standards Institute. Methods for Dilution Antimicrobial Susceptibility Tests for Bacteria That Grow Aerobically; Approved Standard—Ninth Edition; Clinical and Laboratory Standards Institute: Wayne, PA, USA, 2012; Volume 32. [Google Scholar]

| Function | Cefepime | Imipenem | Meropenem | Zinc Oxide |
|---|---|---|---|---|
| Surface area (Approx) (Å2) | 579.69 | 474.86 | 571.50 | 605.19 |
| Surface area (Grid) (Å2) | 703.60 | 544.04 | 620.34 | 465.81 |
| Volume (Å3) | 1226.74 | 871.98 | 1068.58 | 752.79 |
| Hydration energy (Kcal/mole) | −15.20 | −19.58 | −11.69 | −101.84 |
| Log P | 6.79 | 2.87 | 5.68 | 0.50 |
| Refractivity (Å3) | 82.56 | 54.10 | 79.95 | 5.52 |
| Polarizability (Å3) | 45.93 | 29.14 | 38.04 | 2.97 |
| Mass (amu) | 480.56 | 299.34 | 383.46 | 1058.81 |
| Total energy (kcal/mol) | 88.3957 | 53.6913 | 67.7658 | 187.262 |
| Dipole moment (Debye) | 0.3984 | 2.234 | 0.7063 | 1.115 |
| RMS gradient (kcal/Å mol) | 0.09671 | 0.09816 | 0.09849 | 0.08826 |
| Sl. No. | Ligand | Receptor-Chain (A) | Interaction | Distance | E (kcal/mol) | Binding Energy ∆G (Autodock Vina) |
|---|---|---|---|---|---|---|
| Cefepime | N4 19 | OD1 ASN 307 | (A) H-donor | 2.88 | −1.9 | −7.9 |
| N5 27 | OE1 GLU 115 | (A) H-donor | 2.60 | −12.7 | ||
| S2 30 | SD MET 112 | (A) H-donor | 3.49 | −0.5 | ||
| N6 33 | O MET 112 | (A) H-donor | 2.94 | −1.0 | ||
| N6 33 | SD MET 112 | (A) H-donor | 3.34 | −4.5 | ||
| N6 33 | O LEU 113 | (A) H-donor | 2.75 | −5.8 | ||
| C2 52 | OD2 ASP 111 | (A) H-donor | 3.33 | −0.8 | ||
| C2 52 | O GLY 117 | (A) H-donor | 3.17 | −0.7 | ||
| C6 55 | O GLU 115 | (A) H-donor | 3.04 | −1.0 | ||
| O1 2 | NH1 ARG 43 | (A) H-acceptor | 2.77 | −3.7 | ||
| O2 37 | NH1 ARG 80 | (A) H-acceptor | 2.75 | −9.1 | ||
| O2 37 | NH2 ARG 80 | (A) H-acceptor | 2.79 | −4.9 | ||
| O3 38 | NH2 ARG 43 | (A) H-acceptor | 2.68 | −11.6 | ||
| N4 19 | OE1 GLU 115 | (A) ionic | 3.24 | −3.1 | ||
| N4 19 | OE2 GLU 115 | (A) ionic | 3.32 | −2.7 | ||
| N5 27 | OE1 GLU 115 | (A) ionic | 2.60 | −7.8 | ||
| O2 37 | NH1 ARG 80 | (A) ionic | 2.75 | −6.4 | ||
| O2 37 | NH2 ARG 80 | (A) ionic | 2.79 | −6.1 | ||
| O2 37 | NE ARG 131 | (A) ionic | 3.35 | −2.5 | ||
| O2 37 | NH1 ARG 131 | (A) ionic | 3.44 | −2.1 | ||
| O2 37 | NH2 ARG 131 | (A) ionic | 3.17 | −3.4 | ||
| O3 38 | NH1 ARG 43 | (A) ionic | 3.10 | −3.8 | ||
| O3 38 | NH2 ARG 43 | (A) ionic | 2.68 | −7.0 | ||
| O3 38 | NH1 ARG 80 | (A) ionic | 2.94 | −4.9 | ||
| O3 38 | NH2 ARG 80 | (A) ionic | 3.12 | −3.7 | ||
| Imipenem | S1 13 | OD2 ASP 111 | (A) H-donor | 3.65 | −0.7 | −6.4 |
| N2 20 | OE1 GLU 115 | (A) H-donor | 2.80 | −11.7 | ||
| C12 21 | O GLY 117 | (A) H-donor | 3.03 | −2.0 | ||
| N3 24 | O GLU 115 | (A) H-donor | 2.76 | −3.9 | ||
| N3 24 | OD1 ASP 119 | (A) H-donor | 2.81 | −8.9 | ||
| O3 29 | OE2 GLU 115 | (A) H-donor | 2.48 | −0.4 | ||
| O4 28 | NH1 ARG 43 | (A) Hacceptor | 2.87 | −3.7 | ||
| O4 28 | NH2 ARG 43 | (A) Hacceptor | 3.35 | −0.7 | ||
| O3 29 | NH2 ARG 43 | (A) Hacceptor | 2.85 | −1.7 | ||
| O1 37 | NE1 TRP 299 | (A) Hacceptor | 2.89 | −1.2 | ||
| N2 20 | OE1 GLU 115 | (A) ionic | 2.80 | −6.0 | ||
| N3 24 | OD1 ASP 119 | (A) ionic | 2.81 | −5.9 | ||
| Meropenem | C13 22 | OD2 ASP 111 | (A) H-donor | 3.04 | −1.9 | −7.5 |
| N2 24 | OD1 ASP 111 | (A) H-donor | 2.65 | −9.3 | ||
| N2 24 | O GLY 117 | (A) H-donor | 2.71 | −6.2 | ||
| O3 43 | OE1 GLU 115 | (A) H-donor | 2.43 | 6.3 | ||
| O5 31 | NH1 ARG 131 | (A) H-acceptor | 2.88 | −2.2 | ||
| O5 31 | NH2 ARG 131 | (A) H-acceptor | 2.94 | −3.7 | ||
| O4 42 | NH1 ARG 43 | (A) H-acceptor | 2.82 | −3.2 | ||
| O4 42 | NH1 ARG 80 | (A) H-acceptor | 2.88 | −0.9 | ||
| O4 42 | NH2 ARG 80 | (A) H-acceptor | 2.88 | −1.8 | ||
| O2 51 | NE1 TRP 299 | (A) H-acceptor | 2.82 | −1.7 | ||
| N2 24 | OD1 ASP 111 | (A) ionic | 2.65 | −7.3 | ||
| N2 24 | OD2 ASP 111 | (A) ionic | 3.58 | −1.6 | ||
| ZnO | Ionic and hydrophobic interaction | −9.1 | ||||
| Compound | MMGBSA dG Bind(NS) | MMGBSA dG Bind(NS) Coulomb | MMGBSA dG Bind Covalent | MMGBSA dG Bind(NS) Hbond | MMGBSA dG Bind(NS) Lipo | MMGBSA dG Bind(NS) Solv GB | MMGBSA dG Bind(NS) vdW |
|---|---|---|---|---|---|---|---|
| Zinc oxide | 1071.258 | −7842.09 | −107.921 | −168.326 | −612.175 | 8946.66 | 74.61135 |
| Meropenem | −33.7034 | 22.20441 | 0.350149 | −3.27054 | −5.90737 | −23.6331 | −23.4469 |
| Imipenem | −24.3949 | 9.574381 | 0.060334 | −2.54655 | −9.49918 | 3.736621 | −25.7205 |
| Cefepime | −27.8693 | −28.3957 | 1.987949 | −1.02687 | −8.06542 | 45.62215 | −37.9914 |
| Bacterial Code | ZnO-NPs | Cefepime | Meropenem | Imipenem | ||||||||
|---|---|---|---|---|---|---|---|---|---|---|---|---|
| Test | ZI mm | MIC mg\mL | MBC mg\mL | ZI mm | MIC mg\mL | MBC mg\mL | ZI mm | MIC mg\mL | MBC mg\mL | ZI mm | MIC mg\mL | MBC mg\mL |
| KP-ATCC | 26 | 0.2 | 0.5 | 20 | 0.9 | 0.2 | I | <0.25 | 0.5 | R | <1 | 1 |
| KPC | 24 | 0.2 | 0.9 | R | >64 | >64 | R | >16 | >16 | R | >4 | >4 |
Disclaimer/Publisher’s Note: The statements, opinions and data contained in all publications are solely those of the individual author(s) and contributor(s) and not of MDPI and/or the editor(s). MDPI and/or the editor(s) disclaim responsibility for any injury to people or property resulting from any ideas, methods, instructions or products referred to in the content. |
© 2023 by the authors. Licensee MDPI, Basel, Switzerland. This article is an open access article distributed under the terms and conditions of the Creative Commons Attribution (CC BY) license (https://creativecommons.org/licenses/by/4.0/).
Share and Cite
Elsayim, R.; Aloufi, A.S.; Modafer, Y.; Eltayb, W.A.; Alameen, A.A.; Abdurahim, S.A. Molecular Dynamic Analysis of Carbapenem-Resistant Klebsiella pneumonia’s Porin Proteins with Beta Lactam Antibiotics and Zinc Oxide Nanoparticles. Molecules 2023, 28, 2510. https://doi.org/10.3390/molecules28062510
Elsayim R, Aloufi AS, Modafer Y, Eltayb WA, Alameen AA, Abdurahim SA. Molecular Dynamic Analysis of Carbapenem-Resistant Klebsiella pneumonia’s Porin Proteins with Beta Lactam Antibiotics and Zinc Oxide Nanoparticles. Molecules. 2023; 28(6):2510. https://doi.org/10.3390/molecules28062510
Chicago/Turabian StyleElsayim, Rasha, Abeer S. Aloufi, Yosra Modafer, Wafa Ali Eltayb, Alaa Alnoor Alameen, and Samah Awad Abdurahim. 2023. "Molecular Dynamic Analysis of Carbapenem-Resistant Klebsiella pneumonia’s Porin Proteins with Beta Lactam Antibiotics and Zinc Oxide Nanoparticles" Molecules 28, no. 6: 2510. https://doi.org/10.3390/molecules28062510
APA StyleElsayim, R., Aloufi, A. S., Modafer, Y., Eltayb, W. A., Alameen, A. A., & Abdurahim, S. A. (2023). Molecular Dynamic Analysis of Carbapenem-Resistant Klebsiella pneumonia’s Porin Proteins with Beta Lactam Antibiotics and Zinc Oxide Nanoparticles. Molecules, 28(6), 2510. https://doi.org/10.3390/molecules28062510

